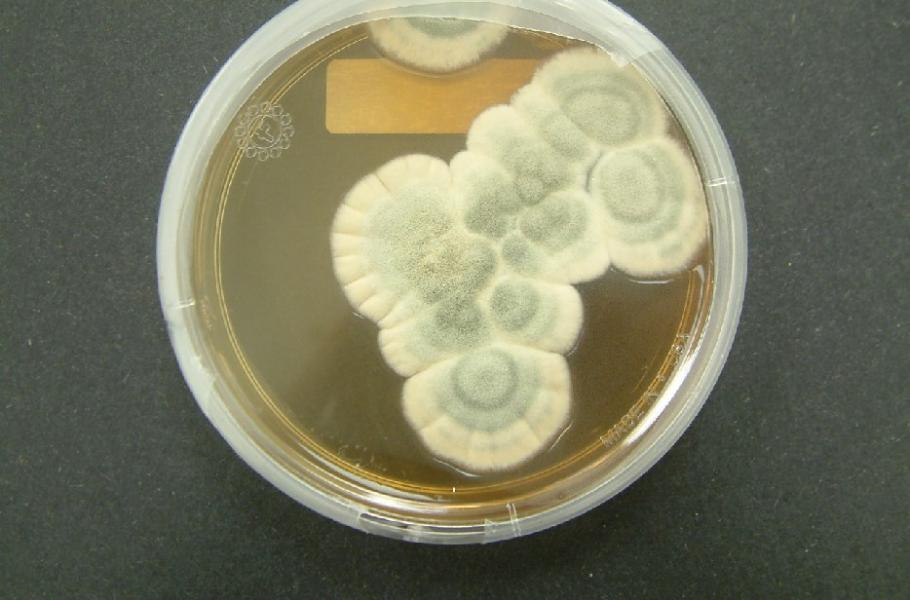

Návrat ke klasice: Vědci oživili původní penicilinovou plíseň Alexandera Fleminga
Přečtení genomu původní plísně, díky které Alexander Fleming objevil penicilin, by mohlo pomoci v boji proti bakteriálním rezistencím
V boji proti rezistentním bakteriím využíváme všechny myslitelné zbraně a triky. Tim Barraclough z britské Oxford University a jeho spolupracovníci nedávno překvapivě zjistili, že ještě nikdo nepřečetl genom původní plísně, kterou proslavil britský mikrobiolog Alexander Fleming.
Ten v roce 1928 úplnou náhodou objevil penicilin, když mu Petriho misky s bakteriemi napadla plíseň štětičkovec Penicillium chrysogenum. Po tomto průlomovém objevu byla původní plíseň z Flemingových Petriho misek zmražena a uchována pro budoucí výzkum. A ten čas podle všeho nadešel.
Odborníci už sice v minulosti vzorky této plísně rozmrazili a nechali plíseň narůst, zatím ale ještě nikdo nepřečetl celý genom Flemingova štětičkovce. Barracloughův tým to po nezbytném oživení štětičkovce udělal. Když měli přečteno, porovnali DNA této původní plísně s genomy dvou moderních kmenů štětičkovce, které se používají v USA k produkci penicilinu.
TIP: Technologie zrozené z války: Náročný boj s neviditelnou armádou
Takové porovnání je velmi cenné a ukazuje, jak se klíčové geny štětičkovce, které jsou zodpovědné za výrobu penicilinu, případně dalších zajímavých látek, změnily od Flemingových časů. Porovnání genomů původního a dnešních štětičkovců také napovídá, jak bychom mohli vylepšit produkci penicilinu nebo i samotný penicilin.